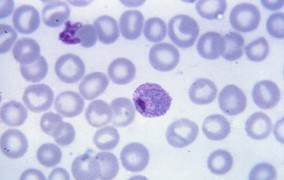

Noticias
-
Descubiertas sustancias relacionadas con la ferocidad de las abejas
16-08-2018Compuestos químicos identificados por científicos de Brasil pueden explicar por qué ciertas abejas menos agresivas se vuelven feroces. Este estudio salió publicado en Journal of Proteome Research -
Demostrada la relación entre dieta intrauterina hipoproteica y cáncer de próstata
09-08-2018Experimentos con ratas indican que esa restricción durante la gestación induce un desequilibrio en los niveles de hormonas sexuales, lo cual parece favorecer el surgimiento de tumores en animales de edad avanzada -
Surge una nueva posibilidad de tratamiento contra la malaria
09-08-2018En pruebas realizadas en ratones y en cultivos in vitro, una molécula diseñada en el Centro de Investigación e Innovación en Biodiversidad y Fármacos de la FAPESP fue capaz de matar al parásito del paludismo -
Una variación genética impide que adolescentes obesos adelgacen
09-08-2018Un estudio realizado en Brasil apunta que un polimorfismo presente en un gen receptor de la leptina modifica el balance energético y la regulación neuroendocrina -
La senda hacia la expansión y la intensificación agropecuaria en Brasil
09-08-2018El fin del desmonte, el uso eficiente de la tierra y la elaboración de sistemas alimentarios más sostenibles requieren de una combinación de factores, dicen científicos de un proyecto apoyado por la FAPESP -
La innovación y los retos del desarrollo regional
09-08-2018Las políticas públicas focalizadas, el compromiso del sector privado y la articulación de redes de negocios contribuyen para disparar el cambio tecnológico, afirman expertos en un debate organizado por la FAPESP -
Un curso lleva a São Paulo los avances en el uso de láseres
09-08-2018Un evento realizado con el apoyo de la FAPESP tuvo entre sus objetivos la consolidación en Brasil del área de fotónica avanzada, cuyo mercado mundial mueve más de 500 mil millones de dólares -
El Fermilab destaca el apoyo de la FAPESP al Dune
09-08-2018Para el laboratorio de Estados Unidos, la colaboración con la comunidad científica brasileña se ha fortalecido merced al incentivo de la Fundación paulista a grandes proyectos como el Deep Underground Neutrino Experiment -
La detección de neutrinos y la materia como destacados en un evento internacional
02-08-2018Científicos y estudiantes de diversos países participan en un curso intensivo organizado por el International Center for Theoretical Physics - South American Institute for Fundamental Research en São Paulo -
Una empresa desarrolla maquetas virtuales interactivas para el mercado inmobiliario
02-08-2018El desafío consistió en crear un producto que generase la misma experiencia que un videojuego, pero que pudiese utilizárselo en dispositivos móviles -
Identificado un gen clave para acelerar el crecimiento de la caña de azúcar
02-08-2018Al manipular la actividad del gen ScGAI en linajes transgénicos de cañamiel, científicos brasileños incrementan sustancialmente el tamaño del tallo de la planta -
El NeuroMat es el mayor productor de contenido de matemática en Wikipedia
02-08-2018La iniciativa del Centro de Investigación, Innovación y Difusión en Neuromatemática (NeuroMat) de la FAPESP creó más de cuatro mil entradas en la enciclopedia online y mejoró más de 21 mil -
Avances en la comprensión del surgimiento de las enfermedades autoinmunes
02-08-2018Científicos brasileños emplean una herramienta de edición en un gen clave para la eliminación de las células autoagresivas y en el control de la aparición de afecciones tales como la diabetes mellitus tipo 1 -
Un estudio muestra de qué manera se replica el virus del Oropouche
02-08-2018Los resultados de una investigación con células humanas se publicaron en la revista PLoS Pathogens, y apuntan potenciales blancos para intentar detener la infección -
Larvas de moscas elaboran una sustancia que puede curar heridas crónicas
02-08-2018En un estudio a cargo del Centro de Toxinas, Respuesta Inmunitaria y Señalización Celular (CeTICS) de la FAPESP se identificó y se secuenció la estructura del péptido sarconesina, que elimina diversos tipos de bacterias -
Un estudio muestra 2000 años de historia de las lluvias en Brasil
26-07-2018Registros isotópicos obtenidos en cavernas revelan cómo varió la distribución de las precipitaciones en el país durante los cambios climáticos globales que afectaron a Europa en la Edad Media -
Elaboran un apósito de alto poder cicatrizante con una proteína de la piña
26-07-2018Investigadores alían los efectos antiinflamatorios de la bromelina con la nanocelulosa bacteriana en un producto que potencializa la cicatrización en cortes, quemaduras e incluso en heridas ulcerativas -
El nivel de melatonina puede indicar el grado de malignidad de ciertos tumores
26-07-2018Investigadores brasileños demuestran que en algunos tipos de cáncer, cuanto mayor es la producción de melatonina de las células tumorales, menos agresiva es la enfermedad y más se prolonga el tiempo de vida del paciente -
Para revolucionar la generación de energía solar
26-07-2018Un grupo internacional de investigación que cuenta con la participación de científicos brasileños obtuvo un nuevo material partiendo del mineral de hierro con aplicaciones como fotocatalizador -
Mosquitos transgénicos pueden ser piezas claves en el combate contra las arbovirosis
26-07-2018Machos con espermatozoides defectuosos podrán utilizarse para reducir la población de Aedes aegypti y en estrategias integradas de control de las epidemias de dengue, chikunguña, zika y fiebre amarilla -
Una empresa brasileña perfecciona la tecnología de ventilación artificial
19-07-2018El monitoreo de la ventilación mecánica con el tomógrafo de impedancia eléctrica desarrollado en la empresa Timpel permite brindarles a los pacientes un tratamiento más seguro -
Expediciones a la Amazonia revelan nuevas especies de sapos, lagartos, aves y plantas
19-07-2018Un equipo encabezado por el zoólogo Miguel Trefaut Rodrigues pretende develar patrones evolutivos de la biota neotropical y las relaciones que mantuvieron en el pasado la Selva Amazónica y el Bosque Atlántico -
Las moléculas de ARN regularían la acción de las hormonas en el cáncer de próstata
19-07-2018En un estudio realizado en Brasil se identificaron centenas de ARNs que no codifican proteínas, pero que parecen regular el efecto de los andrógenos y sus receptores en la expresión génica de los tumores -
Los frentes fríos pueden elevar la mortalidad por ACVs
19-07-2018En un estudio realizado en São Paulo, Brasil, se detectó la relación entre el descenso de la temperatura y el aumento de la cantidad de muertes por accidentes cerebrovasculares, fundamentalmente entre mujeres y ancianos -
Purifican proteínas utilizadas como biosensores mediante un proceso alternativo
19-07-2018El resultado de una colaboración entre científicos Brasil y de Portugal permitirá la aplicación a escala industrial de un método sostenible de purificación de prótidos pegilados -
Las solicitudes de refugio aumentaron 34 veces desde 2010 en Brasil, según un estudio
19-07-2018Para los autores del Atlas Temático Migração Refugiada, una investigación que contó con el apoyo de la FAPESP, el debate sobre la cuestión migratoria es crucial para combatir la xenofobia -
Investigan los hábitos reproductivos del hongo causante del pie de atleta
12-07-2018Análisis genómicos sugieren que la reproducción asexuada es la regla entre los ejemplares de la especie Trichophyton rubrum. Esto debe tenerse en cuenta en el desarrollo de nuevos fármacos -
Tecnología IoT para el monitoreo forestal remoto
12-07-2018El sistema SmartForest se vale de sensores electrónicos para analizar el crecimiento, la calidad y la salud de los árboles -
Los matorrales de altura poseen una gran diversidad de especies de plantas en Brasil
12-07-2018Una edición especial de una revista científica reúne el conocimiento actual sobre la vida vegetal de este ecosistema aún poco estudiado y bajo amenaza, situado en una cadena montañosa llamada Serra do Espinhaço -
La industria automotriz pasa por las mayores transformaciones de las últimas décadas
12-07-2018La entrada en el sector de empresas de tecnología tales como Google, Tesla y Amazon puede contribuir para alterar la estructura y la propia naturaleza del negocio, sostienen investigadores -
Describen el papel de una enzima en la respuesta contra el mal de Chagas
12-07-2018Estudios indican que la expresión de la proteína PI3K gamma aumenta durante la infección provocada por T. cruzi. Esto seria esencial para evitar la inflamación exacerbada y controlar la parasitemia -
Un tratamiento previene los síntomas de la esquizofrenia en pruebas con ratas
12-07-2018Científicos brasileños apuntaron a mimetizar en un modelo animal el estado de niños y adolescentes con riesgo de padecer esta enfermedad en la edad adulta -
Científicos detectan la unión entre el bosón de Higgs y el cuark cima
05-07-2018El registro de este acoplamiento confirma las predicciones teóricas del Modelo Estándar de la Física de Partículas. Y sólo fue posible debido al altísimo nivel de energía que ha alcanzado el colisionador -
Un test para diagnosticar la fibrosis quística con mayor precisión
05-07-2018Desarrollan en Brasil un nuevo método no invasivo para la detección de esta enfermedad genética que desequilibra la concentración de cloro y sodio en las células productoras de secreciones del cuerpo -
Hallan regiones genómicas que podrían aumentar la producción de carne en Brasil
05-07-2018Investigadores de São Paulo descubren seis áreas del genoma de la raza de ganado nelore afectadas por la selección para el peso que pueden llevar a su mejora -
¿De qué manera la esclerosis lateral amiotrófica afecta a las neuronas?
05-07-2018Científicos brasileños desarrollan un modelo para la identificación de alteraciones en las motoneuronas en el estadio presintomático de la enfermedad -
La germinación en la sabana brasileña es única entre los biomas similares en el mundo
05-07-2018Investigadores descubren un patrón germinativo exclusivo de las plantas del Cerrado. Este hallazgo puede ser útil para su preservación: su vegetación actual corresponde tan sólo a un 20% de la originaria -
Un manejo innovador en la cría de tilapias reduce los gastos con alimento balanceado
28-06-2018Es un sistema en el cual se emplean tanques redondos de aluminio que flotan sobre conjuntos de botellas PET -
Bacterias que aumentan la seguridad del consumo de quesos artesanales
28-06-2018Investigadores brasileños identifican cepas de microorganismos lácticos que pueden inhibir el crecimiento de Listeria en quesos frescos brasileños, además de inactivarla en quesos curados y acortar su maduración -
Develan la historia de la diversificación del linaje del terecay
28-06-2018Paleontólogos brasileños dilucidan la zaga evolutiva de una especie de tortuga amazónica y del quelonio más antiguo de Brasil, que habitó en el nordeste del país hace 125 millones de años -
Identifican un biomarcador de la enfermedad hepática grasa no alcohólica
28-06-2018Esta dolencia se relaciona fuertemente con el síndrome de ovario poliquístico, que afecta hasta al 15% de las mujeres en edad reproductiva. Un estudio puede llevar al desarrollo de métodos de diagnóstico menos invasivos -
Los signos vitales del endotelio
28-06-2018En libro un publicado en EE.UU. por científicos brasileños y de otros países se aborda el papel de este órgano en la salud y como indicador de afecciones cardiovasculares, de cáncer y de problemas cognitivos -
La construcción de ciclopistas incentiva el uso de bicicletas en São Paulo
28-06-2018Un estudio de investigadores brasileños indicó que el hecho de vivir cerca de ciclovías y vías segregadas elevó un 154% las probabilidades de utilización de estos vehículos como medio de transporte -
Una empresa produce nanocápsulas de omega-3 para la industria de alimentos
21-06-2018Los fabricantes de helados, chocolatadas, bebidas lácteas, jugos, panes y bizcochuelos constituyen su principal mercado -
Prueban un medicamento para la diabetes contra el cáncer de cabeza y cuello
21-06-2018El uso de metformina quedó asociado a una disminución del riesgo de padecer tumores en un estudio con más de 2.000 participantes realizado en una universidad brasileña -
Miden el riesgo de transmisión del dengue con base en un nuevo indice
21-06-2018Es una metodología desarrollada por científicos brasileños y se basa en el conteo de la cantidad de hembras de Aedes. También se la está probando para medir el mismo riesgo con el zika y el chikunguña -
Demuestran de qué modo la ingestión moderada de alcohol protege el corazón
21-06-2018Un estudio brasileño indica que este efecto se relaciona con la activación de la enzima ALDH2, encargada de librar al organismo de las moléculas tóxicas que se conocen con el nombre de aldehídos -
Un estudio apunta quiénes son los “dueños” del carbono en Brasil
21-06-2018Pese a que el Estado es el principal responsable de las reservas de vegetación autóctona, alrededor del 20% de ese stock de carbono se encuentra desprotegido, según científicos brasileños y suecos -
Monitoreo del nivel de los basureros para optimizar la recolección de residuos
14-06-2018Un sistema diseñado por una empresa brasileña optimiza el trayecto de los camiones y disminuye los gastos con logística y combustible, además de reducir las emisiones de contaminantes -
Una proteína de araña puede curar el cáncer que diezma al demonio de Tasmania
14-06-2018Un tipo de tumor altamente contagioso que aún carece de tratamiento pone en riesgo a esta especie australiana. Pero una molécula descubierta por científicos en Brasil puede llegar a frenar su proliferación
Lo más visto
-
El organismo aprovecha poco de los minerales de las nueces, apunta un estudio que simuló la digestión humana
11-06-2026
-
Nuevo dinosaurio de cuello largo encontrado en Maranhão era pariente cercano de una especie europea
07-05-2026
-
‘Andamio’ de grafeno recluta células óseas y ayuda al organismo a regenerar fracturas
02-04-2026
-
Investigación muestra que las áreas húmedas del Cerrado almacenan más carbono que los bosques de la Amazonía
11-06-2026
-
En un experimento, truchas amarillas crecen más que las de línea salvaje
07-05-2026
-
Una investigación combina sabor y valor nutricional en el chocolate amazónico
19-03-2026
-
Estudio alerta sobre los riesgos nutricionales del uso prolongado del medicamento omeprazol
05-02-2026
-
Un trabajo sugiere un camino para viabilizar el uso de estados de Majorana en la computación cuántica
23-04-2026
-
Científicos utilizan ultrasonido para hacer estallar virus de la influenza A y de la COVID-19 sin dañar células humanas
07-05-2026
-
Vómito fosilizado revela el primer pterosaurio filtrador de los trópicos
22-01-2026